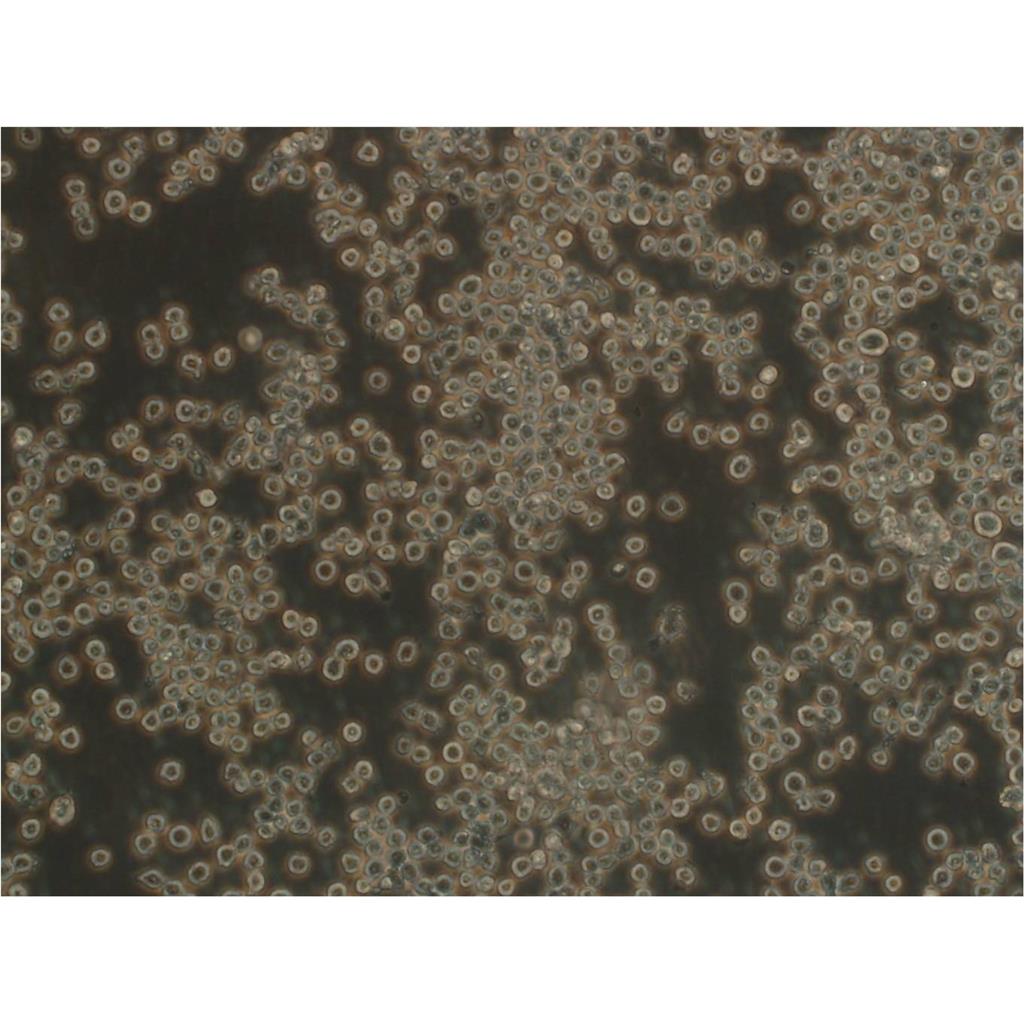
LLC-PK1 Cells猪肾细胞专业保种|STR图谱

"LLC-PK1 Cells猪肾细胞专业保种|STR图谱
【形态特性】
LLC-PK1 Cells猪肾细胞专业保种|STR图谱上皮细胞样或成纤维细胞样或淋巴母细胞样
【污染检测】
支原体、细菌、酵母和真菌检测为阴性。
【LLC-PK1 Cells猪肾细胞专业保种|STR图谱英文别名】
LLC-PK(1); LLC-PK-1; LLC PK-1; LLc-PK1; LLC PK1; LLCPK1; Lilly Laboratories Culture-Porcine Kidney 1
【生长特性】
LLC-PK1 Cells猪肾细胞专业保种|STR图谱贴壁生长或悬浮生长
【空泡现象】
在密集培养时,细胞中可见巨大的空泡,这是细胞的正常特性,无需担心。
细胞的冻存是细胞培养技术中至关重要的环节,其目的在于长期保存细胞活性、维持细胞特性,并为后续实验提供稳定可靠的细胞来源。在生物医学研究等领域,细胞冻存技术的规范操作直接关系到实验结果的可靠性和可重复性。细胞冻存的核心原理是通过低温环境(通常为-196℃液氮)使细胞代谢活动近乎停止,从而实现长期保存。当温度降至-130℃以下时,细胞内所有生化反应基本停滞,理论上可实现永久保存。冻存过程中,保护剂通过降低冰晶形成对细胞的物理损伤,维持细胞膜完整性。研究表明,规范冻存的细胞在复苏后仍能保持原始特性达10年以上。
【细胞培养经验分享】启蒙老师的重要性:一般进实验室都有师兄师姐带着做,他们就是你做细胞的启蒙老师。他们的操作手法、细节、理论讲解就成了你操作的准则,如营养液、细胞瓶的摆放位置、灭菌处理程序、开盖手法、细胞吹打手法等等。要学会他们的正确操作,在第一次的时候就要重视。像养孩子一样养细胞,细胞有时真的很脆弱,最好每天都去看看它,以防止出现培养箱缺水、缺二氧化碳、停电、温度不够等异常现象,也好及时解决这些意外,避免重复实验带来的更大痛苦。好细胞要及时保种:细胞要分批传代,这样即使有一批出了问题,还有一批备用的。像后者一般人可能不容易做到。
【血清比例】
使用10%-20%的血清浓度有助于优化LLC-PK1 Cells猪肾细胞专业保种|STR图谱实验条件,提高实验的重复性和稳定性。这一浓度范围经过多年实验和实践的验证,被认为是较为适宜的选择。
【操作规范】
在细胞培养和处理过程中,需严格遵守无菌操作规范,以避免细胞污染和交叉污染。
【消化条件】
室温下用胰酶消化1-3分钟。
【细胞传代】
传代时,应使用适量的胰蛋白酶溶液进行消化,并在显微镜下观察细胞消化情况。消化下来的细胞容易成团,需要吹打吹散。传代后,应确保细胞均匀分布在培养瓶或培养皿中。
【生物安全等级】
1级。
【换液周期】
LLC-PK1 Cells猪肾细胞专业保种|STR图谱每周2-3次
细胞传代步骤(二):终止消化:当观察到大部分细胞已经脱落时,向培养皿中加入适量的完全培养基以终止胰蛋白酶的消化作用。细胞悬液转移与离心:用吸管轻轻吹打培养皿底部的细胞,使其形成均匀的细胞悬液。然后,将细胞悬液转移至无菌离心管中,以适当的转速(通常为800-1000rpm)离心3-5分钟。重悬与接种:离心后,轻轻倒掉上清液,用适量的完全培养基重悬细胞沉淀。根据实验需要,将细胞悬液按照适当的比例接种到新的培养皿或培养瓶中,置于37℃、5% CO2的培养箱中继续培养。
实验人员需佩戴防爆面罩及双层无菌手套,尤其当发现冻存管液氮渗入时(管壁出现冰晶凝结为典型标志)。建议使用专门设计的液氮罐提取器,避免徒手接触-196℃的冻存管导致低温灼伤。解冻前准备37℃恒温水浴锅,水位需完全浸没冻存管液面线以上,并预热至温度稳定(±0.5℃波动范围)。
【产品包装】
复苏发货:LLC-PK1 Cells猪肾细胞专业保种|STR图谱T25培养瓶(一瓶)或冻存发货:1ml冻存管(两支)
【物种来源】
LLC-PK1 Cells猪肾细胞专业保种|STR图谱来源于人源、鼠源等其它物种来源
【细胞冻存】
待细胞生长状态良好时,可进行细胞冻存。一般使用冻存液进行冻存,并置于液氮中储存。
【细胞接收流程】
收到细胞后,应首先观察细胞状态,然后进行75%酒精消毒处理。将细胞置于37℃培养箱中放置2-4小时以稳定LLC-PK1 Cells猪肾细胞专业保种|STR图谱状态。当细胞密度达到80%-90%时,即可进行首次传代培养。
【消化传代】
使用0.25%胰酶-EDTA溶液,37°C孵育1-2分钟,轻拍培养瓶促进细胞脱落。(悬浮细胞可省略这步操作)
【传代比例】
1:2-1:4(LLC-PK1 Cells猪肾细胞专业保种|STR图谱首次传代建议1:2)
【背景信息】
LLC-PK1 Cells猪肾细胞专业保种|STR图谱详见相关文献介绍
【细胞状态】
传代和消化过程中,应密切关注细胞状态,避免过度消化或机械损伤导致细胞活性下降。
【培养条件】
37°C、5%CO₂、饱和湿度环境,使用含10%-20%FBS的基础培养基。
【来源说明】
LLC-PK1 Cells猪肾细胞专业保种|STR图谱主要来源ATCC、ECACC、DSMZ、RCB等细胞库
【污染防控】
严格无菌操作,定期检测支原体污染,必要时使用双抗预防细菌污染。
【培养观察】
定期观察LLC-PK1 Cells猪肾细胞专业保种|STR图谱生长状态,注意培养基的pH值变化和细胞密度,及时换液和传代。
【细胞复苏】
复苏细胞时,应快速将冻存管从液氮中取出并置于37℃水浴中解冻,然后转移到含新鲜培养基的无菌管中并吹打混匀。整个复苏过程应尽可能在5-10分钟内完成,以确保细胞的高存活率。
胰蛋白酶消化作为细胞传代的标准操作,其时间与浓度控制存在严格的金标准。实验数据显示,当消化时间超过常规需求的1.5倍时,细胞表面黏附分子会出现不可逆损伤,导致30-50%的细胞发生异常聚集。这种聚集并非简单的物理现象,而是细胞应激反应激活的表现。建议采用""预冷终止法"":在显微镜下观察到80%细胞回缩时,立即加入4℃预冷血清培养基,并配合轻柔吹打(不超过10次)可显著降低聚集率。高浓度血清虽然能促进细胞增殖,但也可能带来一些潜在风险。其中最主要的风险是可能诱导细胞分化。血清中含有多种生长因子和激素,这些物质在浓度过高时可能改变细胞的原始特性。特别是对于需要保持未分化状态的干细胞,这种影响尤为显著。因此,在使用高浓度血清时,必须密切监测细胞的形态和标志物表达,确保其特性不发生改变。
SW13 Cells人肾上腺皮质小细胞癌细胞专注复苏|STR图谱
Ishikawa Cells人子宫内膜癌细胞专注复苏|STR图谱
SH-SY5Y Cells人神经母细胞瘤细胞专注复苏|STR图谱
CCD-18Co Cells人结肠组织细胞专注复苏|STR图谱
OCI-LY-8细胞专业保种;背景说明:弥漫大B淋巴瘤;传代方法:1:2-1:3传代;每周换液2-3次。;生长特性:悬浮;形态特性:详见产品说明书;相关产品有:SKO007细胞、NCI-H2591细胞、HOP-62细胞
MAVER-1细胞专业保种;背景说明:详见相关文献介绍;传代方法:1:3-1:5传代;2-3天换液1次。;生长特性:悬浮生长;形态特性:淋巴母细胞;相关产品有:AML-193细胞、NCI-H2170细胞、SNU-520细胞
HT-1376细胞专业保种;背景说明:详见相关文献介绍;传代方法:1:2传代;生长特性:贴壁生长;形态特性:详见产品说明书;相关产品有:SUSM1细胞、NCI-H716细胞、KBM7细胞
H-520细胞专业保种;背景说明:详见相关文献介绍;传代方法:1:3-1:6传代;2-3天换液1次;生长特性:贴壁或悬浮,详见产品说明书部分;形态特性:详见产品说明书;相关产品有:QGP-1细胞、UPCI-SCC090细胞、CPAE细胞
MRASMC细胞专业保种;背景说明:详见相关文献介绍;传代方法:1:2-1:3传代;每周换液2-3次。;生长特性:贴壁或悬浮,详见产品说明书部分;形态特性:详见产品说明书;相关产品有:Tohoku Hospital Pediatrics-1细胞、EC9706细胞、CCD-18Co细胞
RTgill-W1[ATCC CRL-2523] Cells鱼鳃细胞专注复苏|STR图谱
NCI-H441 Cells人肺腺癌细胞专注复苏|STR图谱
SH-SY5Y Cells人神经母细胞瘤细胞专注复苏|STR图谱
BT-549 Cells人乳腺管癌细胞专注复苏|STR图谱
bEnd.3 Cells小鼠脑血管内皮瘤细胞专注复苏|STR图谱
HCC827+luc Cells人非小细胞肺癌细胞专注复苏|STR图谱
K7M2wt+luc Cells小鼠骨肉瘤成骨细胞专注复苏|STR图谱
NCI-H102细胞专业保种;背景说明:详见相关文献介绍;传代方法:1:3传代,2-3天传一代;生长特性:悬浮生长 ;形态特性:圆形;淋巴母细胞样;相关产品有:KHYG1细胞、B/C3T3细胞、WIL2 S细胞
H9 AAVS1-TRE3G-NGN2 RETREG3-/- RETREG2-/- RETREG1-/- TEX264-/- Keima-REEP5 Cells(提供STR鉴定图谱)
HAP1 REPS1 (-) 2 Cells(提供STR鉴定图谱)
HEL-92细胞专业保种;背景说明:详见相关文献介绍;传代方法:每周2-3次。;生长特性:悬浮生长;形态特性:成淋巴细胞;相关产品有:Hs 737.T细胞、NCIH1184细胞、PT-K75细胞
C3H/10T1/2-clone8细胞专业保种;背景说明:详见相关文献介绍;传代方法:1:2-1:3传代;每周换液2-3次。;生长特性:贴壁或悬浮,详见产品说明书部分;形态特性:详见产品说明书;相关产品有:MSF细胞、SW-962细胞、NSC-34细胞
BNL-CL.2细胞专业保种;背景说明:详见相关文献介绍;传代方法:1:2传代;生长特性:贴壁生长 ;形态特性:详见产品说明书;相关产品有:NW-MEL-38细胞、HSF细胞、P31-FUJ细胞
CATH.a细胞专业保种;背景说明:神经;SV40转化;C57BL/6 x DBA/2;传代方法:1:2-1:3传代;每周换液2-3次。;生长特性:贴壁;形态特性:详见产品说明书;相关产品有:ECC 12细胞、NCIADRRES细胞、SUP-M2细胞
Hs 27细胞专业保种;背景说明:包皮;成纤维细胞;男性;传代方法:1:2-1:3传代;每周换液2-3次。;生长特性:贴壁;形态特性:详见产品说明书;相关产品有:TE-13细胞、A101D细胞、HEP-3B2细胞
HCCC-9810 Cells人胆管细胞型肝癌细胞专注复苏|STR图谱
CHO-DXB11 CTLA4 Ig-24 Cells仓鼠卵巢细胞专注复苏|STR图谱
COLO 320 Cells人结直肠腺癌细胞专注复苏|STR图谱
LLC-PK1 Cells猪肾细胞专业保种|STR图谱
C127 Cells小鼠乳腺癌细胞专注复苏|STR图谱
HAPI Cells大鼠小胶质细胞专注复苏|STR图谱
SUM 190PT细胞专业保种;背景说明:乳腺癌;女性;传代方法:1:2-1:3传代;每周换液2-3次。;生长特性:贴壁;形态特性:详见产品说明书;相关产品有:LS174T细胞、HeLaS3细胞、NE-1细胞
Capan-2细胞专业保种;背景说明:详见相关文献介绍;传代方法:1:2-1:4传代,2-3天换液1次。;生长特性:贴壁生长;形态特性:多边形;相关产品有:H-1341细胞、NOR 10细胞、NG10815细胞
PL-45细胞专业保种;背景说明:详见相关文献介绍;传代方法:1:2传代;生长特性:贴壁生长;形态特性:上皮样;相关产品有:KPNRTBM1细胞、SAOS 2细胞、DHL-4细胞
HuT-12 Cells(提供STR鉴定图谱)
LA8 Cells(提供STR鉴定图谱)
MuM-2C Cells(提供STR鉴定图谱)
NCI-H2052 Cells人肺间皮瘤细胞专注复苏|STR图谱
E14 Cells小鼠胚胎干细胞专注复苏|STR图谱
AtT-20 Cells小鼠垂体瘤细胞专注复苏|STR图谱
P3X63Ag8.653 Cells小鼠骨髓瘤细胞专注复苏|STR图谱
U-138 MG Cells人脑星形胶质母细胞瘤细胞专注复苏|STR图谱
3T3-L1 Cells小鼠胚胎成纤维细胞专注复苏|STR图谱
NCI-H460 Cells人大细胞肺癌细胞专注复苏|STR图谱
LLC-PK1 Cells猪肾细胞专业保种|STR图谱
KLE Cells人子宫内膜癌细胞专注复苏|STR图谱
ORMES-6 Cells(提供STR鉴定图谱)
RP1-hiPSC11 Cells(提供STR鉴定图谱)
HEK293 CCDC150 KO Cells(提供STR鉴定图谱)
WEHI-231 Cells(提供STR鉴定图谱)
HG01172 Cells(提供STR鉴定图谱)
D283 Med细胞专业保种;背景说明:详见相关文献介绍;传代方法:每周换液2-3次。;生长特性:悬浮细胞的多细胞聚集体,和一些贴壁 Cells;形态特性:上皮细胞;相关产品有:253JB-V细胞、L 428细胞、BC3H1细胞
H-1155细胞专业保种;背景说明:详见相关文献介绍;传代方法:每周换液2-3次。;生长特性:悬浮生长;形态特性:上皮细胞;相关产品有:143BTK-细胞、LN 229细胞、hADSCs细胞
SUDHL5细胞专业保种;背景说明:详见相关文献介绍;传代方法:1:2-1:3传代;每周换液2-3次。;生长特性:贴壁或悬浮,详见产品说明书部分;形态特性:详见产品说明书;相关产品有:T98-G细胞、NEC-8细胞、KP 4细胞
Tb 1-Lu细胞专业保种;背景说明:肺;传代方法:1:2-1:3传代;每周换液2-3次。;生长特性:贴壁;形态特性:详见产品说明书;相关产品有:BNL-HCC细胞、NCIH1688细胞、GM07404D细胞
A375-RFP Cells人黑色素瘤细胞专注复苏|STR图谱
AE-2 Cells小鼠杂交瘤细胞专注复苏|STR图谱
MDA-MB-231-GFP Cells人乳腺癌细胞专注复苏|STR图谱
SNU-475 Cells人肝癌细胞专注复苏|STR图谱
CHO-DXB11 CTLA4 Ig-24 Cells仓鼠卵巢细胞专注复苏|STR图谱
KE-39细胞专业保种;背景说明:详见相关文献介绍;传代方法:1:2-1:3传代;每周换液2-3次。;生长特性:贴壁或悬浮,详见产品说明书部分;形态特性:详见产品说明书;相关产品有:Hs706T细胞、SUP-B1细胞、T47D:A细胞
KE-39细胞专业保种;背景说明:详见相关文献介绍;传代方法:1:2-1:3传代;每周换液2-3次。;生长特性:贴壁或悬浮,详见产品说明书部分;形态特性:详见产品说明书;相关产品有:Hs706T细胞、SUP-B1细胞、T47D:A细胞
SKGT4细胞专业保种;背景说明:详见相关文献介绍;传代方法:1:2-1:3传代;每周换液2-3次。;生长特性:贴壁或悬浮,详见产品说明书部分;形态特性:详见产品说明书;相关产品有:BEND细胞、HCC15细胞、CCRF SB细胞
NOR10细胞专业保种;背景说明:详见相关文献介绍;传代方法:1:2-1:3传代;每周换液2-3次。;生长特性:贴壁或悬浮,详见产品说明书部分;形态特性:详见产品说明书;相关产品有:NCI-SNU-387细胞、SL-29细胞、UM-UC14细胞
NCI-H1299细胞专业保种;背景说明:这株细胞来源于一个淋巴结转移。患者接受了初期放疗。细胞均一性的部分缺失p53蛋白,并缺少p53蛋白表达。细胞可以合成0.1pmol/毫克蛋白的NMB蛋白,而不合成促胃液释放肽(GRP)。;传代方法:1:2传代;3天传代一次。;生长特性:贴壁生长;形态特性:上皮样;多角形;相关产品有:COR-L23细胞、Madison 109细胞、C643细胞
NG 108-15细胞专业保种;背景说明:详见相关文献介绍;传代方法:1:2-1:3传代;每周换液2-3次。;生长特性:贴壁或悬浮,详见产品说明书部分;形态特性:详见产品说明书;相关产品有:GM03569B细胞、MDA-MB-436细胞、A431细胞
Kato-III细胞专业保种;背景说明:详见相关文献介绍;传代方法:1:2传代。3天内可长满。;生长特性:贴壁生长;形态特性:上皮细胞;相关产品有:Ramos 1细胞、Mel-RM细胞、ME180细胞
HS68 Cells人龟头细胞专注复苏|STR图谱
Pt K1 Cells袋鼠肾细胞专注复苏|STR图谱
Kit 225 K6细胞专业保种;背景说明:详见相关文献介绍;传代方法:1:2-1:3传代;每周换液2-3次。;生长特性:贴壁或悬浮,详见产品说明书部分;形态特性:详见产品说明书;相关产品有:H-1385细胞、251 MG细胞、VMM5细胞
MDAPCa2b细胞专业保种;背景说明:详见相关文献介绍;传代方法:1:2-1:4传代,2-3天换液1次。;生长特性:贴壁生长;形态特性:上皮细胞;相关产品有:TE3细胞、JM1细胞、Lieming Xu-2细胞
GA-10-Clone-4细胞专业保种;背景说明:详见相关文献介绍;传代方法:每2-3天换液;生长特性:悬浮生长 ;形态特性:淋巴母细胞样;相关产品有:MGH-U3细胞、NCIH2135细胞、SKLMS-1细胞
WM 2664细胞专业保种;背景说明:详见相关文献介绍;传代方法:1:2传代;生长特性:贴壁生长;形态特性:详见产品说明书;相关产品有:TE-9细胞、SK-MEL24细胞、MV411细胞
T78-1 Cells(提供STR鉴定图谱)
LMTK-细胞专业保种;背景说明:详见相关文献介绍;传代方法:1:2-1:3传代;每周换液2-3次。;生长特性:贴壁或悬浮,详见产品说明书部分;形态特性:详见产品说明书;相关产品有:ECV细胞、MUM2B细胞、MOLM-13细胞
HuO9细胞专业保种;背景说明:详见相关文献介绍;传代方法:1:2-1:3传代;每周换液2-3次。;生长特性:贴壁或悬浮,详见产品说明书部分;形态特性:详见产品说明书;相关产品有:SW1990细胞、MDA-436细胞、BT.549细胞
PT-K75细胞专业保种;背景说明:详见相关文献介绍;传代方法:1:2传代;生长特性:贴壁生长;形态特性:成纤维细胞样;相关产品有:KBM5细胞、NCIH548细胞、HMVEC细胞
CEM/C1 Cells人急性淋巴细胞白血病细胞专注复苏|STR图谱
Panc02 Cells小鼠胰腺癌细胞专注复苏|STR图谱
LLC-PK1 Cells猪肾细胞专业保种|STR图谱
LX-2+GFP Cells人肝星状细胞专注复苏|STR图谱
U87 MG-GFP Cells人恶性胶质瘤细胞专注复苏|STR图谱
SNU-1 Cells人胃癌细胞专注复苏|STR图谱
University of Michigan-Urothelial Carcinoma-14细胞专业保种;背景说明:肾癌;男性;传代方法:1:2-1:3传代;每周换液2-3次。;生长特性:贴壁;形态特性:详见产品说明书;相关产品有:Fortner's melanotic melanoma #3细胞、3T3-442A细胞、HCCC9810细胞
MCF 7B细胞专业保种;背景说明:浸润性导管癌;胸腔积液转移;女性;传代方法:1:2-1:3传代;每周换液2-3次。;生长特性:贴壁;形态特性:详见产品说明书;相关产品有:J-111细胞、CCD 1112SK细胞、Hep 2细胞
H-719细胞专业保种;背景说明:小细胞肺癌;骨髓转移;女性;传代方法:1:2-1:3传代;每周换液2-3次。;生长特性:半贴壁;形态特性:详见产品说明书;相关产品有:Caki2细胞、H1155细胞、HuT 102细胞
DU-4475细胞专业保种;背景说明:详见相关文献介绍;传代方法:每周换液2—3次;生长特性:悬浮,多细胞聚集;形态特性:上皮细胞样;相关产品有:HCC1359细胞、CCD 841 CoTr细胞、HSKMC细胞
HB 611细胞专业保种;背景说明:肝母细胞癌;男性;传代方法:1:2-1:3传代;每周换液2-3次。;生长特性:贴壁;形态特性:详见产品说明书;相关产品有:RPMI #1846细胞、CAL12T细胞、H2405细胞
MB39细胞专业保种;背景说明:脑瘤;传代方法:1:2-1:3传代;每周换液2-3次。;生长特性:贴壁;形态特性:详见产品说明书;相关产品有:Mc Ardle 7777细胞、3AA细胞、COR-L51细胞
SHG44细胞专业保种;背景说明:SHG-44细胞株源自一例2-3级前沿淋巴结星细胞瘤。染色体组型显示89.2%的超三倍体。在Wistar大鼠和裸鼠中接种都能成功。细胞含有神经系统特有的S-100蛋白和星细胞特有的GFA蛋白;传代方法:消化3-5分钟。1:2。3天内可长满。;生长特性:贴壁生长;形态特性:成纤维细胞样;相关产品有:HEK293S细胞、CFSC-2G细胞、Douglas Foster-1细胞
AMO1细胞专业保种;背景说明:浆细胞骨髓瘤;女性;传代方法:1:2-1:3传代;每周换液2-3次。;生长特性:半贴壁;形态特性:详见产品说明书;相关产品有:RKO-AS-45-1细胞、PANC 327细胞、RPMI no. 8226细胞
alpha TC1-6细胞专业保种;背景说明:胰岛素瘤;a细胞;C57BL/6xDBA/2;传代方法:1:2-1:3传代;每周换液2-3次。;生长特性:贴壁;形态特性:详见产品说明书;相关产品有:SKGT2细胞、GTL-16细胞、SNU-C1细胞
MGH-U3 (RN)细胞专业保种;背景说明:详见相关文献介绍;传代方法:1:2-1:3传代;每周换液2-3次。;生长特性:贴壁或悬浮,详见产品说明书部分;形态特性:详见产品说明书;相关产品有:SW 48细胞、NCI-H1793细胞、SkChA1细胞
"